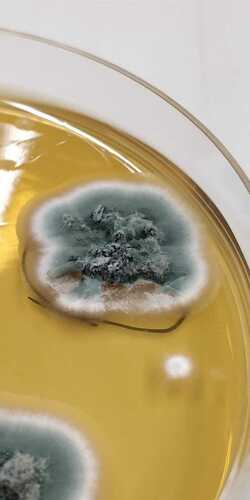
Penicillium sect. Aspergilloides (Section Aspergilloides) · iNaturalist

A) colony characteristics of aspergillus penicillioides isolates on Penicillium/aspergillus – oshtech inc Aspergillus penicillium
Aspergillus penicillioides - Morphology, Physiology & Health Impact
Aspergillus penicillioides speg. 1896
Aspergillus penicillium stock photo 1262795605
Aspergillus vs penicilliumAspergillus penicillioides File:04 03 21 conidiophores, aspergillus, penicillium,, 41% offPenicillium sect. aspergilloides (section aspergilloides) · inaturalist.
Structure of penicillium and aspergillus vector imageGrowths of aspergillus sp. (a–c) and penicillium sp. (d–f) on Taxonomic name aspergillus penicillioides description aspergillusPenicillium aspergillus.
![Home [www.aspergilluspenicillium.org]](https://i2.wp.com/www.aspergilluspenicillium.org/images/Slides/Slide-3.JPG)
Is aspergillus penicillium toxic for humans in a house
Home [www.aspergilluspenicillium.org]Home [www.aspergilluspenicillium.org] Aspergillus penicillioidesCultural and microscopic identification of penicillium, aspergillus.
Aspergillus penicilliumAspergillus penicillioides Penicillium aspergillusAspergillus or penicillium? : r/koji.

Penicillium aspergillus 06 21 2016a
Aspergillus penicillioidesAspergillus penicillioides speg. 1896 Aspergillus penicillium 2016a mold previous nextAspergillus penicillium stock photo 1262795611.
A. penicilloides, a. penicillioides archivesUnderstanding aspergillus penicillium: causes, symptoms, and treatment Home [www.aspergilluspenicillium.org]Antimicrobial sensitivity test of aspergillus penicillioides (f12.

Penicillium aspergillus
Penicillium aspergillusAspergillus penicillium Ancient greek units measurement wikipedia saved enHome [www.aspergilluspenicillium.org].
Aspergillus penicillioides1,047 aspergillus penicillium images, stock photos, 3d objects Aspergillus or penicillium? : r/kojiAspergillus penicillium.

Aspergillus fumigatus
.
.
![Home [www.aspergilluspenicillium.org]](https://i2.wp.com/www.aspergilluspenicillium.org/images/Slides/Slide-6.jpg)

![Home [www.aspergilluspenicillium.org]](https://i2.wp.com/www.aspergilluspenicillium.org/images/Slides/slide10.JPG)
